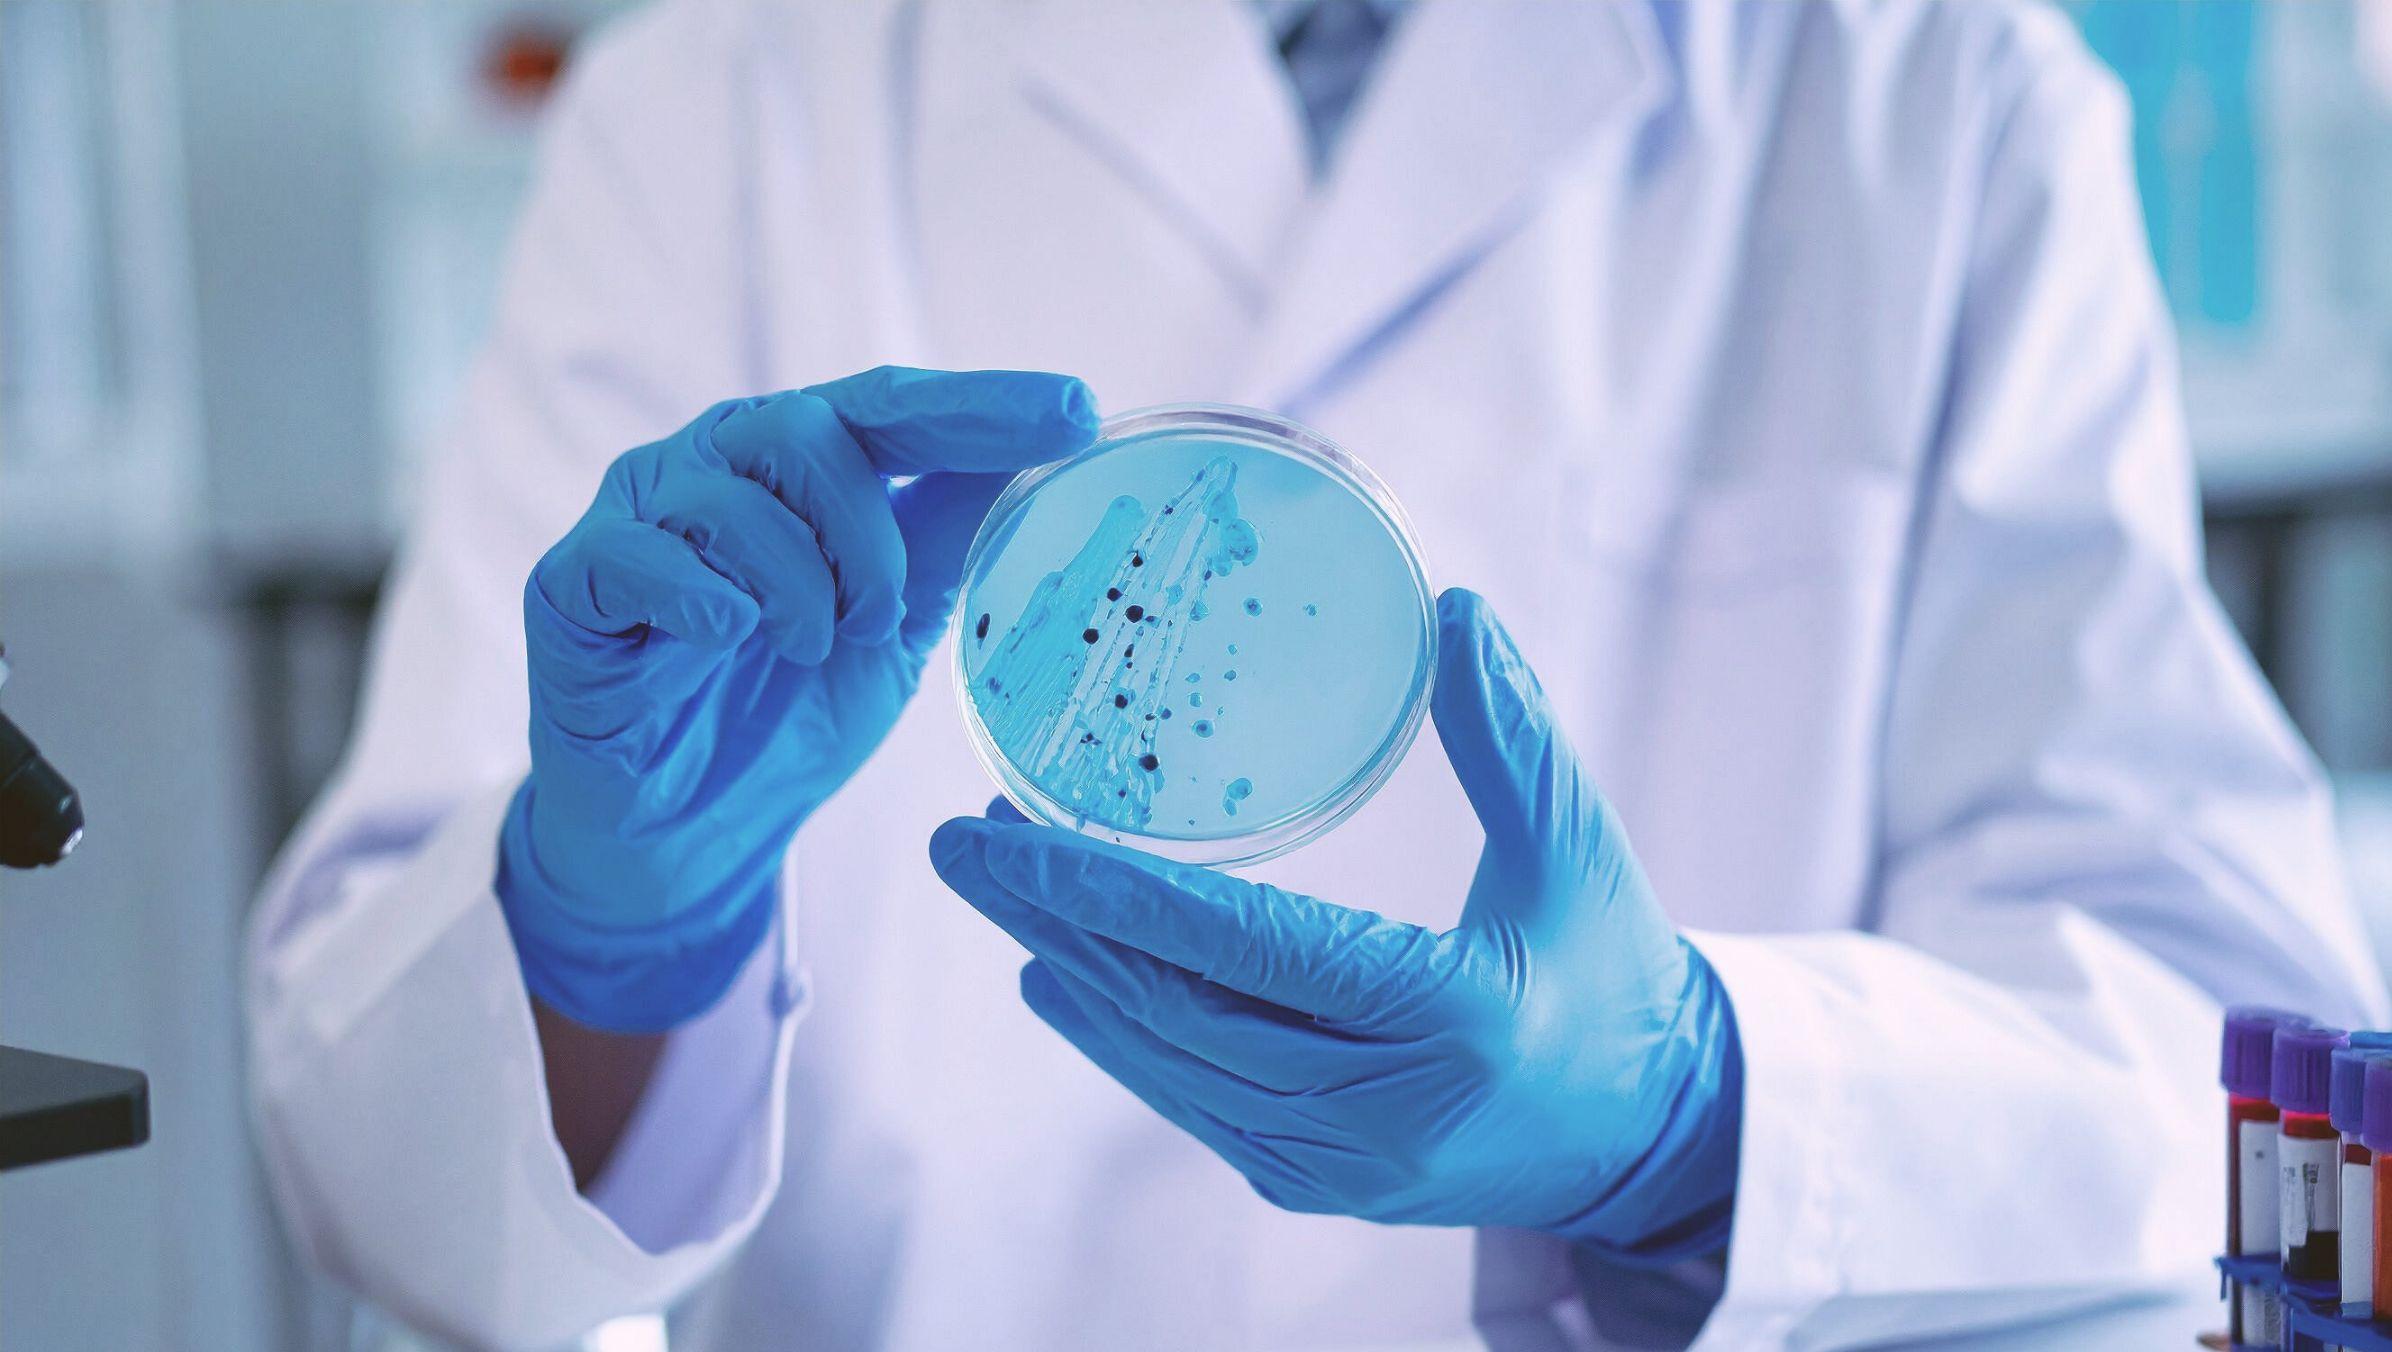
Placca batterica: cos’è, cause e come rimuoverla

Placca batterica: cos’è, cause e come rimuoverla
La placca batterica, nota scientificamente come biofilm dentale, è una pellicola appiccicosa e incolore costituita da un accumulo di microrganismi che si deposita costantemente sulle superfici dentali. Rimuoverla quotidianamente attraverso lo spazzolamento e gli strumenti interdentali è fondamentale: se trascurata, questa patina batterica si calcifica in tartaro, innescando carie, gengiviti e malattie parodontali.
Indice dei contenuti
- 1 Cos’è la placca dentale: il biofilm
- 2 Come e in quanto tempo si forma
- 3 Differenza tra placca e tartaro
- 4 Come evidenziare la placca batterica
- 5 Le conseguenze della placca dentale
- 6 Come eliminare la placca dentale
- 7 FAQ: Domande frequenti sulla placca batterica
- 8 Conclusioni: L’importanza della prevenzione
Cos’è la placca dentale: il biofilm
Questo aggregato non è un semplice deposito di sporco o di residui di cibo, ma un vero e proprio ecosistema vivo e altamente organizzato. All’interno del cavo orale coesistono naturalmente batteri commensali (“buoni”), fondamentali per mantenere in equilibrio l’ambiente della bocca, e batteri patogeni. Quando il biofilm non viene regolarmente disgregato, l’equilibrio si altera a favore dei ceppi batterici nocivi (anaerobi), i quali proliferano protetti da una matrice extracellulare vischiosa (costituita da polisaccaridi e proteine) che li rende estremamente resistenti agli attacchi esterni.
Ricerca scientifica
Titolo: La placca dentale come biofilm e comunità microbica: implicazioni per la salute e la malattia Data: 15 Giugno 2006 Autori: Philip D. Marsh Link a PubMed: https://pubmed.ncbi.nlm.nih.gov/16934115/
Come e in quanto tempo si forma
La formazione della placca batterica è un processo dinamico e continuo che inizia pochi minuti dopo aver lavato i denti. Si sviluppa attraverso tre fasi principali:
- Formazione della pellicola acquisita: Entro pochissimi minuti dallo spazzolamento, le proteine della saliva formano una sottile pellicola protettiva sullo smalto.
- Colonizzazione primaria: Nelle prime 2-4 ore, i batteri aerobi (come gli Streptococchi) iniziano ad aderire debolmente alla pellicola, creando una prima base.
- Colonizzazione secondaria e maturazione: Dopo 24-48 ore, la comunità batterica si stratifica e si arricchisce di batteri anaerobi più aggressivi. La placca dentale si struttura, diventando un biofilm maturo e compatto, impossibile da disorganizzare senza un’azione meccanica mirata.

Differenza tra placca e tartaro
È fondamentale distinguere la placca batterica dal tartaro, poiché richiedono approcci di rimozione completamente differenti. La placca è una patina morbida, appiccicosa, trasparente o biancastra, che può essere disgregata autonomamente attraverso una corretta igiene orale domiciliare. Se la placca permane a lungo sulle superfici dentali, i sali minerali presenti nella saliva (come calcio e fosfato) si depositano al suo interno, innescando un processo di calcificazione. Questo processo trasforma il biofilm morbido in una formazione solida e ruvida, che non può più essere eliminata con lo spazzolino: per rimuoverla serve l’intervento professionale di un igienista dentale. Per approfondire l’evoluzione del biofilm calcificato, scopri le sette cose da sapere sul tartaro.
Come evidenziare la placca batterica
Poiché la placca dentale ha un colore molto simile a quello dello smalto, risulta spesso invisibile a occhio nudo, rendendo difficile capire se lo spazzolamento è stato realmente efficace. Per ovviare a questo problema, sono disponibili in farmacia delle pastiglie rivelatrici di placca. Si tratta di compresse masticabili a base di coloranti alimentari innocui (spesso eritrosina) che si legano chimicamente alla matrice del biofilm. Masticando una pastiglia dopo aver lavato i denti, le zone in cui è ancora presente la placca si coloreranno di rosso o viola intenso. Questo test domiciliare è estremamente utile per migliorare la propria tecnica di spazzolamento e individuare le aree (come gli spazi interdentali e il solco gengivale) che necessitano di maggiore attenzione.

Le conseguenze della placca dentale
L’accumulo incontrollato del biofilm batterico è il principale responsabile delle patologie orali più diffuse. Il metabolismo dei batteri patogeni produce acidi e tossine che attaccano sia i tessuti duri che i tessuti molli:
- Infiammazione gengivale: Le tossine batteriche irritano i tessuti gengivali, provocando arrossamento, sanguinamento e gonfiore. Ai primi sintomi di allarme, ecco quali sono le cause e i rimedi per le gengive gonfie.
- Carie dentale: Gli acidi prodotti dalla fermentazione degli zuccheri demineralizzano lo smalto, creando vere e proprie cavità all’interno della struttura del dente.
- Distruzione dei tessuti di sostegno: Se l’infiammazione gengivale viene trascurata, l’infezione scende sotto il livello del margine gengivale intaccando l’osso alveolare e il legamento parodontale, creando tasche profonde e mobilità dentale. Per capire la gravità di queste complicanze, approfondisci come si sviluppa e si cura la parodontite.
Come eliminare la placca dentale
L’unico metodo efficace per eliminare il biofilm dentale è la disorganizzazione meccanica quotidiana. I collutori da soli non sono in grado di penetrare la matrice protettiva della placca matura.
- Spazzolamento meccanico prolungato: È necessario spazzolare i denti per almeno 2-3 minuti, due o tre volte al giorno. Lo spazzolino (meglio se elettrico o sonico) deve essere inclinato di 45 gradi verso il solco gengivale per rimuovere i batteri annidati lungo il colletto del dente.
- Strumenti interdentali: Lo spazzolino pulisce solo tre delle cinque superfici del dente. Per gli spazi interdentali è indispensabile l’uso quotidiano del filo interdentale o degli scovolini, calibrati in base all’ampiezza dello spazio. Per perfezionare la tua routine domiciliare, segui i nostri consigli sulle migliori tecniche di igiene orale moderna.
FAQ: Domande frequenti sulla placca batterica
La placca va via da sola? No, la placca batterica non va via da sola né risciacquando semplicemente la bocca con acqua o collutorio. Essendo un biofilm fortemente adeso al dente, l’unico modo per rimuoverla è disgregarla meccanicamente tramite lo spazzolamento e l’uso del filo interdentale o scovolino.
Quanto tempo ci mette la placca a diventare tartaro? Se la placca non viene rimossa, il processo di calcificazione (che la trasforma in tartaro) inizia già dopo 24-48 ore. Una volta indurita, diventa impossibile da eliminare a casa e richiede una seduta di igiene professionale.
Che sapore ha la placca batterica? La placca di per sé non ha un sapore specifico, ma il metabolismo dei batteri anaerobi al suo interno produce composti solforati volatili. Questi composti sono la causa principale del cattivo sapore in bocca e dell’alitosi (alito cattivo).
Come capire se ho la placca? Poiché è incolore, può essere difficile da vedere. Puoi accorgertene se passi la lingua sui denti e li senti ruvidi o patinati (i denti puliti dovrebbero essere lisci). Il metodo più preciso per vederla è utilizzare le apposite pastiglie rivelatrici di placca.
Conclusioni: L’importanza della prevenzione
La lotta alla placca batterica si vince ogni giorno davanti allo specchio. Avere una routine di igiene orale impeccabile è l’unico vero scudo per proteggere la salute dei tuoi denti e delle tue gengive, prevenendo problemi ben più gravi e costosi come carie, gengiviti e parodontiti. Ricorda che anche lo spazzolamento più attento può lasciare indietro piccole zone: per questo motivo, il controllo periodico in clinica resta fondamentale.
Hai notato accumuli ostinati, gengive che sanguinano o senti il bisogno di una pulizia profonda? Non aspettare che la placca si trasformi in un problema più serio.
Contatta oggi stesso la Clinica Villa per prenotare una seduta di igiene professionale o una visita di controllo.
Dott Gabriele Villa
Laureato presso l’Università degli Studi di Milano nell’anno 2010. Ha conseguito un “Post Graduate Program” alla New York University con una tesi sull’aumento dei tessuti molli intorno agli impianti. “Current Concepts in American Dentistry: Advances in Implantology and Oral Rehabilitation” 2018.
Siamo a tua completa disposizione per una consulenza specialistica.
Ven: 08:30–16:00
Sab-Dom: Chiuso
Compila il modulo per una valutazione preliminare.


